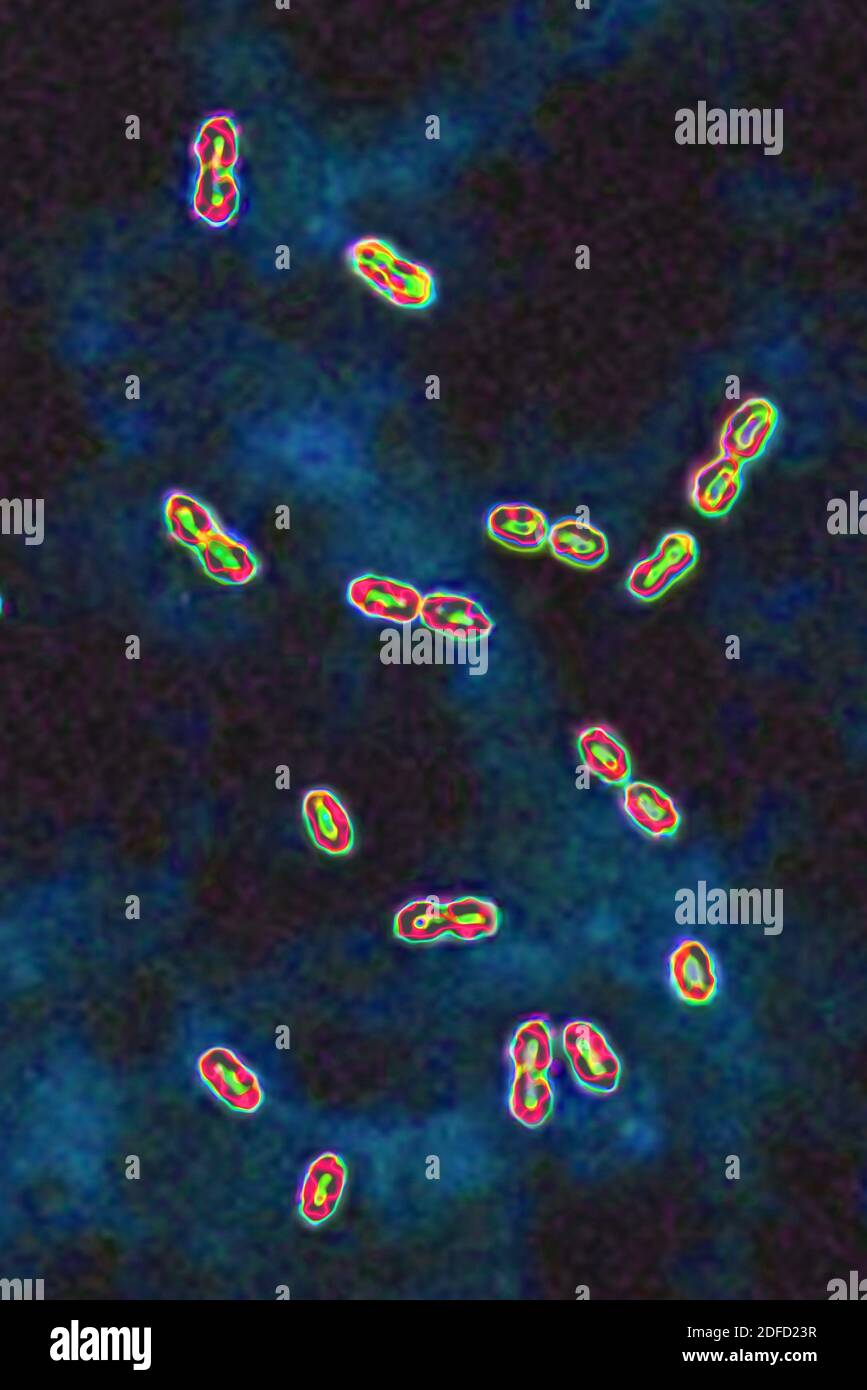
Bactéries pneumococciques Banque D'Images

Infection pulmonaire Photos Stock & Des Images
(43)Infection pulmonaire Photos Stock & Des Images

RM2RF8HPX–Pneumonie du poumon droit (infection respiratoire aiguë) révélée par une radiographie thoracique frontale.

RM2RF8HR9–Pneumonie du poumon droit (infection respiratoire aiguë) révélée par une radiographie thoracique frontale.

RM2RF8HPN–Pneumonie du poumon droit (infection respiratoire aiguë) révélée par une radiographie thoracique frontale.